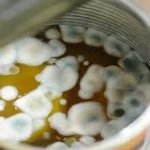

وكالة تليسكوب الاخبارية
توفي طفل يبلغ من العمر ٣ أعوام جراء تعرضه للسقوط عن سطح منزل ذويه في منطقة الشونه الشمالية.
هذا وإسعف طفل عصر الخميس إلى طوارئ مستشفى معاذ بن جبل الحكومي جراء تعرضه للسقوط عن سطح المنزل ما ان لبث وفارق الحياه.
وقال مصدر بأنه تم تحويل الجثه إلى الطب الشرعي لتحديد سبب الوفاة وفتحت الاجهزة الامنية تحقيقا بالحادث.